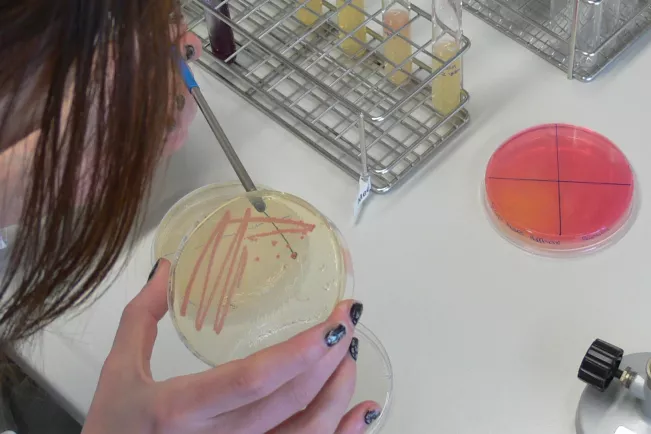
fb05_bio_med_mibi.jpg (DE)

Department of Natural Sciences
Medical Microbiology
Lecture
Compulsory Course
- in BSc Applied Biology, 3rd Semester (Winter Term)
- 6 h/week (2L/2E/2P)
- Credits: 6 ECTS
Content of the Lecture:
- Definitions and terms of Medical Microbiology
- The normal human flora: tissue tropism, microbial metabolism, health-promoting and damaging effects of the human microbiom
- Disease Development: transmission, attachment to and invasion into the host, bacterial evasion from the immune system
- Toxins: classification, mode of action, pharmaceutical use
- Antibiotics: classification, mode of action, area of use
- Infectious diseases of the skin, the gastrointestinal- and urogenital tract, the cardiovascular system, the nervous system, and the respiratory tract: pathogens, modes of transmission, symptoms/disease, virulence factors and therapy
Exercises
Content of the Exercises:
- Repetition of the content of the lectures
- Stimulation of critical thinking
- Gaining background information about Medical Microbiology topics by internet search
- Connecting information from different resources
Internship
Content of the Practical Course
1. Normal Skin Flora
2. Respiratory Microorganisms
3. Bacteria of the Mouth
4. Bacteria of the Urogenital Tract
5. Clinical Unknown Identification
6. Epidemiology: Staphylococcus Carrier Study
7. Lancefield Grouping of Pathogenic Streptococci with Latex Slide Agglutination Test
Requirements
- Enrolment in the 3. semester of the Applied Biology program at Bonn-Rhein-Sieg University of Applied Sciences.
- Successful attendance of the General Safety Instructions (part of the Introduction Weeks, always in September/October) and the Special Safety Instructions (S1 and L2).
Information For New Students: You have to attend these instructions before you are allowed to participate in any practical course of this university. Please ask for the dates in advance! - Microbiology Practice (if necessary evidence), e.g. successfull participating in 2nd semester course "Microbiology".
Successful participation in Written Exam and in Practical Course.
Written Exam: 60%
Practical Course: 40%
Literature
- Tortora, Funke & Case: Microbiology. An Introduction. Pearson Education Limited; ISBN: 1292026308
- Greenwood: Medical Microbiology. Churchill Livingstone; ISBN-10: 0702040908
- Brooks & Carroll: Jawetz, Melnick, & Adelberg's Medical Microbiology. Mcgraw-Hill Education Ltd; ISBN-10: 0071790314
- Murray: Medical Microbiology. Mosby; ISBN: 0323086926
Sie haben noch Fragen?

Dieter Reinscheid
Professor for Microbiology and Biotechnology, Chairperson of the Examination Board
Location
Rheinbach
Room
K 212
Address
von-Liebig-Str. 20
53359, Rheinbach
Telephone
+49 2241 865 588
Location
Rheinbach
Room
Büro: A 208; Labor: F 005; F 007 oder F 009
Address
von-Liebig-Str. 20
53359, Rheinbach
Telephone
+49 2241 865 571 oder 567Links
Further links